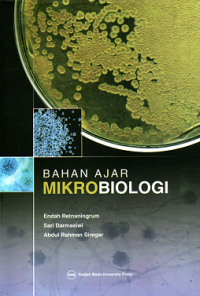
Bahan Ajar Mikrobiologi

Buku
Bahan Ajar Mikrobiologi
Tidak Tersedia Deskripsi
Ketersediaan
#
UPT. Perpustakaan Akper Al Hikmah 2 Brebes (Ilmu Biomedik Dasar)
614 END b c1
2014
Tersedia
#
UPT. Perpustakaan Akper Al Hikmah 2 Brebes (Ilmu Biomedik Dasar)
614 END b c2
2015
Tersedia
#
UPT. Perpustakaan Akper Al Hikmah 2 Brebes (Ilmu Biomedik Dasar)
614 END b c3
2016
Tersedia
Informasi Detail
- Judul Seri
-
-
- No. Panggil
-
616.01 END b
- Penerbit
- Yogyakarta : Gajah Mada University Press., 2021
- Deskripsi Fisik
-
xvi + 170 hlm.; 15,5 x 23 cm
- Bahasa
-
Indonesia
- ISBN/ISSN
-
978-602-386-175-0
- Klasifikasi
-
616.01
- Tipe Isi
-
text
- Tipe Media
-
-
- Tipe Pembawa
-
-
- Edisi
-
-
- Subjek
- Info Detail Spesifik
-
-
- Pernyataan Tanggungjawab
-
Endah Retnaningrum, Sari Darmasiwi, Abdul Rahman Siregar
Versi lain/terkait
Tidak tersedia versi lain
Lampiran Berkas
Tidak Ada Data
Komentar
Anda harus masuk sebelum memberikan komentar
Karya Umum
Karya Umum  Filsafat
Filsafat  Agama
Agama  Ilmu-ilmu Sosial
Ilmu-ilmu Sosial  Bahasa
Bahasa  Ilmu-ilmu Murni
Ilmu-ilmu Murni  Ilmu-ilmu Terapan
Ilmu-ilmu Terapan  Kesenian, Hiburan, dan Olahraga
Kesenian, Hiburan, dan Olahraga  Kesusastraan
Kesusastraan  Geografi dan Sejarah
Geografi dan Sejarah